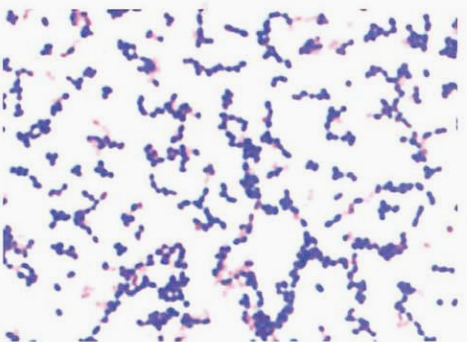
图 1粪肠球菌纯培养的镜下形态(革兰染色)
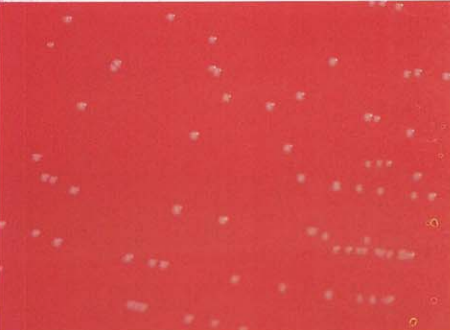
图 3粪肠球菌在血琼脂平板上的菌落特征(18~24h)
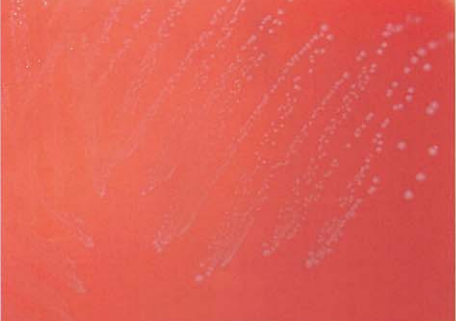
图 8屎肠球菌在血琼脂平板上的菌落特征(18~24h)
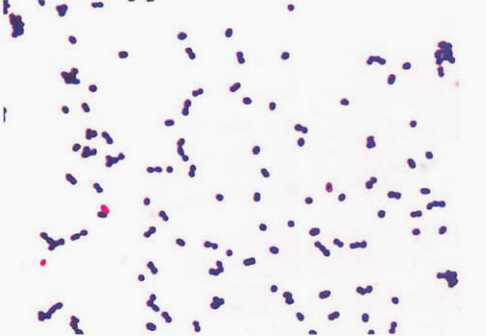
图 10 铅黄肠球菌纯培养的镜下形态(革兰染色)
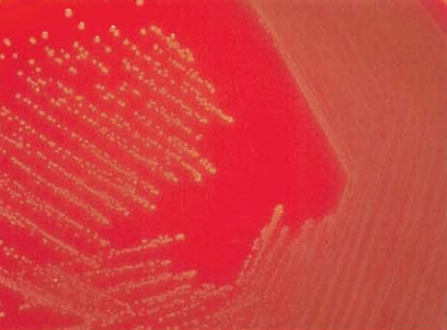
图 11铅黄肠球菌在血琼脂平板上的菌落特征(18~24h)
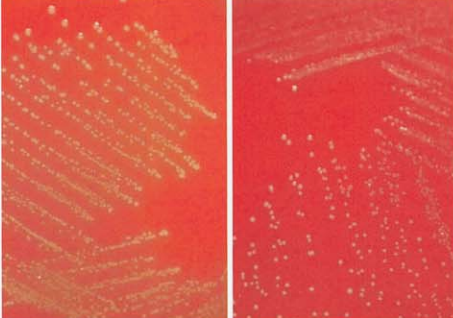
图  13 铅黄肠球菌与鹑鸡肠球菌在血琼脂平板上的菌落特征左图为铅黄肠球菌:右图为鹑鸡肠球菌
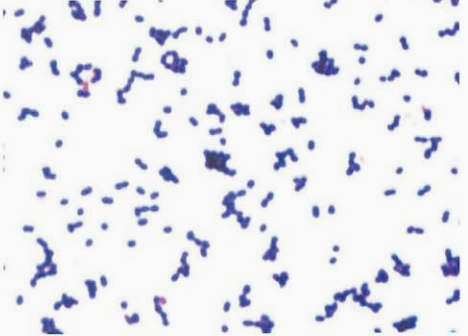
图 14 鹑鸡肠球菌纯培养的镜下形态(革兰染色)
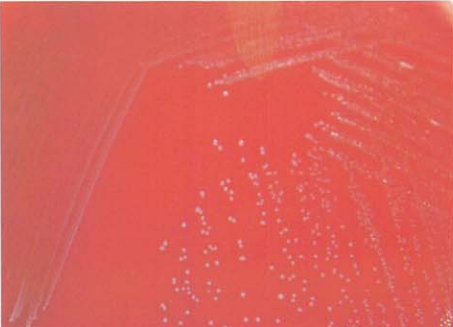
图 15 鹑鸡肠球菌在血琼脂平板上的菌落特征(18~24h)

肠球菌属的形态与生化反应
来源:武汉市灰藻生物科技有限公司 浏览量:362 发布时间:2026-01-12 20:32:00
肠球菌属包括,粪肠球菌(E. faecalis)、屎肠球菌(E. faecium)、驴肠球菌(E. asini)、鸟肠球菌(E. avium)、鼠肠球菌(E. ratti)、鹑鸡肠球菌(E. gallinarum)、鸽肠球菌(E. columbae)、犬肠球菌(E. canis)、木戴胜鸟肠球菌(E. phoeniculicola)、假鸟肠球菌(E. pseudovium)、铅黄肠球菌(E. casseliflavus)、盲肠肠球菌(E. cecorum)、殊异肠球菌(E. dispar)、耐久肠球菌(E. durans)、浅黄色肠球菌(E. flavescens)、亮黄肠球菌(E. pallens)、浅黄肠球菌(E. gilvus)、血过氧化物肠球菌(E. haemoperoxidus)、病臭肠球菌(E. malodoratus)、莫拉维亚肠球菌(E. moraviensis)、蒙氏肠球菌(E. mundtii)、棉子糖肠球菌(E. raffinosus)、解糖肠球菌(E. saccharolyticus)、硫黄肠球菌(E. sulfurous)、肠绒毛肠球菌(E. villosum)、戴维斯肠球菌(E. devriesei)、赫尔曼肠球菌(E. hermanniensis)、海水肠球菌(E. aquimarinus)、E. sanguinicola、E. thailandicus、E. canintestini等40余种。
一、粪肠球菌 E. faecalis
(一)粪肠球菌形态与染色
革兰阳性球菌,单个、成双或短链排列(图 1),菌血症或脓毒血症患者血培养标本涂片查见革兰阳性球菌(图 2)。
图 1粪肠球菌纯培养的镜下形态(革兰染色)

图 2 粪肠球菌血培养标本的涂片(革兰染色)
(二)粪肠球菌培养特性
在血琼脂平板上35℃培养18~24 h,形成较小、灰白色、湿润、凸起、有α或γ溶血环的菌落(图 3)。在麦康凯琼脂平板上形成较小、干燥、粉红色菌落(图 4)。
图 3粪肠球菌在血琼脂平板上的菌落特征(18~24h)

图 4 粪肠球菌在麦康凯琼脂平板上的菌落特征(18~24h)
(三)粪肠球菌生化反应
触酶试验阴性,6.5% NaCl肉汤中生长,多数菌株PYR试验、胆汁七叶苷试验阳性,对杆菌肽耐药。主要生化反应见表 1。
| 试验 | 结果 | 试验 | 结果 |
|---|---|---|---|
| 甘露醇 | +* | 色素 | - |
| 山梨糖 | - | 蔗糖 | +* |
| 精氨酸双水解酶 | + | 丙酮酸盐 | + |
| 阿拉伯糖 | - | MGP | - |
| 海藻糖 | + | 鼠李糖 | - |
| 木糖 | -* | 0.04%亚碲酸盐生长 | + |
| GAL | - |
注:+,90%或以上的菌株呈阳性;-,90%或以上的菌株呈阴性。MGP,甲基-α-D-吡喃葡萄糖苷;GAL,2-萘基-b-d-吡喃半乳糖苷。*,偶见个别(<3%)的菌株表现出非典型反应)
(四)粪肠球菌鉴别要点
- 本菌特征 革兰阳性球菌,触酶试验阴性,6.5% NaCl肉汤中生长,胆汁七叶苷试验阳性,45℃中生长。
- 与链球菌属和乳球菌属的鉴别 肠球菌属能在pH9.6肉汤和45℃中生长,胆汁七叶苷和NaCl(盐)耐受试验阳性,而链球菌属和乳球菌属则相反。
- 与铅黄肠球菌、鹑鸡肠球菌的鉴别 见表 2。
| 菌名 | 色素 | 阿拉伯糖 | 山梨醇 | 棉子糖 | 动力 | MGP | 木糖 |
|---|---|---|---|---|---|---|---|
| 铅黄肠球菌 | +* | + | V | + | +* | + | + |
| 粪肠球菌 | - | + | - | - | - | - | -* |
| 鹑鸡肠球菌 | - | - | + | + | +* | + | + |
注:+,90%以上菌株阳性;-,90%以上菌株阴性;V,11%~89%菌株阳性。MGP,甲基-α-D-吡喃葡萄糖苷。*,偶见个别(<3%)的菌株表现出非典型反应)
- 与葡萄球菌属的鉴别 两者镜下形态略相似,但肠球菌属单个、成双或短链排列,触酶试验阴性,葡萄球菌属以葡萄串状排列为主,触酶试验阳性(图 5)。
图 5粪肠球菌及金黄色葡萄球菌镜下形态的鉴别(革兰染色)左侧为粪肠球菌,右侧为金黄色葡萄球菌
- 与无色藻菌和片球菌的鉴别 粪肠球菌发酵葡萄糖产酸不产气,PYR试验阳性;无色藻菌发酵葡萄糖产酸产气,PYR试验阴性,精氨酸双水解酶试验阳性;片球菌发酵葡萄糖产酸不产气,PYR阴性,精氨酸双水解酶阳性。
- 与相关革兰阳性球菌的鉴别 见表 3。
| 菌名 | 甘露醇 | 山梨糖 | 精氨酸双水解酶 | 阿拉伯糖 | 山梨醇 | 棉子糖 | 0.04%亚硝酸盐生长 | 动力 | 色素 | 蔗糖 | 丙酮酸盐 | MGP | 海藻糖 | 木糖 | GAL |
|---|---|---|---|---|---|---|---|---|---|---|---|---|---|---|---|
| Ⅰ群 | |||||||||||||||
| 鸟肠球菌 | + | + | — | + | + | — | — | — | — | + | + | V | + | — | — |
| 棉子糖肠球菌 | + | + | — | + | + | + | — | — | — | + | + | V | + | — | — |
| 苍黄肠球菌 | + | + | — | — | + | + | — | — | + | + | + | V | + | — | — |
| 淡黄肠球菌 | + | + | — | + | + | + | — | — | + | + | + | + | + | — | — |
| 解糖肠球菌* | + | + | — | — | + | + | — | — | — | + | — | + | + | — | + |
| 恶臭肠球菌 | + | + | — | — | + | + | — | — | + | + | V | + | V | + | — |
| 解脲肠球菌 | + | + | — | — | + | — | — | + | — | + | V | + | — | — | — |
| 假鸟肠球菌 | + | + | — | — | + | — | — | — | V | — | + | + | V | — | V |
| 德氏肠球菌 | + | + | — | — | + | — | — | — | — | + | — | + | — | — | — |
| 夏成夷肠球菌 | + | + | — | — | + | — | — | — | — | + | — | — | + | — | — |
| Ⅱ群 | |||||||||||||||
| 屎肠球菌 | +d | — | +d | + | V | V | — | +d | — | +d | V | — | + | -d | V |
| 铅黄肠球菌 | + | — | +d | + | V | + | — | +d | +d | + | V | + | + | + | — |
| 鹑鸡肠球菌 | + | — | +d | + | — | + | — | — | +d | + | V | + | + | + | V |
| 粪特肠球菌 | + | — | + | + | V | + | — | — | + | + | V | + | + | — | V |
| 孔肠球菌 | + | — | +d | — | — | — | — | — | +d | — | — | + | — | — | + |
| 血肠球菌* | +d | — | +d | — | — | — | — | — | + | — | — | + | -d | — | — |
| 血过氧化氢肠球菌* | + | — | +r | — | — | — | — | — | — | — | + | + | + | — | — |
| 罗塔肠球菌* | + | — | + | — | — | — | — | + | + | — | — | + | — | — | — |
| 泰国肠球菌 | + | — | + | — | — | — | — | — | — | — | V | — | — | + | — |
| 孔球菌属 | + | — | + | — | — | — | — | — | — | — | — | V | — | — | — |
| Ⅲ群 | |||||||||||||||
| 殊异肠球菌 | — | — | + | — | — | + | — | — | — | + | + | + | -d | — | — |
| 狗肠球菌 | — | — | + | — | — | + | — | — | — | + | + | + | — | — | — |
| 小肠肠球菌 | — | — | + | — | — | + | — | — | — | + | — | — | + | — | V |
| 纽比克肠球菌 | — | — | + | — | — | — | — | — | — | — | — | — | -d | — | V |
| 坚韧肠球菌 | — | — | + | — | — | — | — | — | — | — | — | V | — | + | — |
| 鼠肠球菌 | — | — | + | — | — | — | — | — | — | — | — | — | V | — | — |
| 粗毛肠球菌 | — | — | + | — | — | — | — | — | — | — | — | — | — | — | — |
| Ⅳ群 | |||||||||||||||
| 海水肠球菌* | — | — | — | + | — | + | — | — | — | + | — | + | + | — | — |
| 味本鸟肠球菌 | — | — | — | — | — | + | — | — | — | + | V | + | + | + | — |
| 百荫肠球菌 | — | — | — | — | — | + | — | — | — | + | + | — | + | — | — |
| 放线肠球菌 | — | — | — | — | — | + | — | — | + | + | V | — | + | — | — |
| 砂肠球菌* | — | — | — | — | — | — | — | — | — | + | — | +r | + | — | — |
| 类便肠球菌 | — | — | — | — | — | — | — | — | + | — | +r | + | — | — | — |
| 西里西亚肠球菌 | — | — | — | — | — | — | — | — | + | — | +r | + | — | — | — |
| 白蚁肠球菌 | — | — | — | — | — | — | — | — | — | + | — | — | + | — | — |
| Ⅴ群 | |||||||||||||||
| 狗肠球菌* | + | — | — | + | — | — | — | — | — | + | + | V | + | + | — |
| 鸽肠球菌* | + | — | — | — | — | + | — | — | — | + | V | V | + | + | — |
| 莱蒙球菌* | + | — | — | — | — | — | — | — | — | + | — | + | + | + | V |
| 摩拉维亚肠球菌 | + | — | — | — | — | — | — | — | — | + | — | — | + | — | V |
| 藤肠球菌* | + | — | — | — | — | — | — | — | — | + | — | — | — | — | — |
| 茶肠球菌* | + | — | — | — | — | — | — | — | — | + | + | + | + | — | — |
| 赫曼肠球菌 | + | — | — | — | — | — | — | — | — | — | — | — | + | — | — |
| 意大利肠球菌 | V | — | — | — | V | — | — | — | — | + | + | + | + | — | — |
| 翠鸟肠球菌 | + | — | — | — | — | — | — | — | — | + | — | + | + | + | + |
| 尤里卡肠球菌* | + | — | — | — | — | + | — | — | — | + | — | + | +r | + | + |
| 植物肠球菌* | + | — | — | — | — | — | — | — | + | + | — | — | +d | + | — |
| 小溪肠球菌* | + | — | — | — | — | + | — | — | — | + | — | + | + | + | — |
| 维吉肠球菌* | + | — | — | — | — | — | — | — | — | — | V | — | + | — | — |
| 河流漫游球菌 | + | — | — | — | — | + | — | — | + | — | + | — | + | + | — |
| 注:+,90%或以上的菌株呈阳性;—,90%或以上的菌株呈阴性;V,可变(11%~89%的菌株阳性);c,表型特征基于典型菌株的数据;d,偶见个例(<3%的菌株表现出非典型反应);e,延迟反应(培养3日或更长时间);f,弱。MGP,甲基-α-D-吡喃葡萄糖苷;GAL,2-硝基-b-d-吡喃半乳糖苷 | |||||||||||||||
7.与其他菌属的鉴别 见表 4。
| 菌名 | 溶血 | 葡萄糖产气 | PYR | LAP | 胆汁七叶苷 | 6.5% NaCl生长 | 动力 | 万古霉素 |
|---|---|---|---|---|---|---|---|---|
| 肠球菌属 | α、γ | − | + | + | + | V | − | S |
| 链球菌属 | α、β、γ | − | − a | + | − b | − | − | S |
| 乳球菌属 | α、γ | − | + | + | + | V | − | S |
| 漫游球菌属 | α、γ | − | + | + | + | + | + | S |
| 无色藻菌属 | α、γ | + | − | + | V | V | − | R |
| 乏养球菌属 | α、γ | − | + | − | − | − | − | S |
| 学生球菌属 | α、γ | − | + | V | − | − | − | S |
| 片球菌属 | α | − | − | + | + | V | − | R |
| 气球菌属 | α | − | + | − | V | + | − | S |
| 创伤弧菌属 | γ | − | + | − | + | + | − | S |
| 注:+:90%以上菌株阳性;−:90%以上菌株阴性;V:11%~89%菌株阳性;S:敏感;R:耐药。a. α群链球菌等PYR阳性,其他链球菌阴性;b. 在草绿色链球菌中有5%~10%的胆汁七叶苷阳性。LAP,亮氨酸氨基肽酶 | ||||||||
(五) 粪肠球菌药敏试验的药物种类选择
粪肠球菌药敏试验的药物种类选择,见表 5。
| 抗菌药物名称 | |
|---|---|
| 必选 | 青霉素、氨苄西林 |
| 可选 | 万古霉素、达托霉素、利福平、利奈唑胺、奎奴普丁-达福普汀、特地唑胺 |
| 天然耐药 | 头孢菌素类、氨基糖苷类*、克林霉素*、甲氧苄啶、复方磺胺甲噁唑*、夫西地酸、氨曲南、多黏菌素B/黏菌素、萘啶酸 |
注: *对于肠球菌属,头孢菌素类、氨基糖苷类抗菌药物(除高水平耐药筛查)及克林霉素和复方新诺明体外试验可表现出活性,但临床无效,所以不应报告敏感。建议尿道感染报告的药物: 四环素、环丙沙星、诺氟沙星、左氧氟沙星、呋喃妥因。具体参照CLSI M100-S27最新版本文件
(六) 粪肠球菌结果解释与要点提示
粪肠球菌和屎肠球菌主要引起医院感染,最常见的为尿道感染(大部分与尿道器械操作、导尿等有关),其次为腹部和盆腔等部位的创伤和外科术后感染。近年来,肠球菌属氨苄西林耐药株和庆大霉素高耐药株逐渐增多,耐万古霉素的肠球菌国外也有较多报道,已使肠球菌所致重症感染的治疗成为临床棘手的问题。
从痰液、粪便中分离出肠球菌一般无需报告,除非痰液分离出的占绝对优势的仅为肠球菌则须报告。尿液标本中分离出的肠球菌(单一菌种)且菌落计数≥104CFU/ml也具有临床意义。对于血培养和脑脊液培养分离出的肠球菌,需做β-内酰胺酶检测,若β-内酰胺酶阳性,则对氨基青霉素、羧基青霉素和脲基青霉素均耐药。在我国,粪肠球菌和屎肠球菌对高浓度庆大霉素的耐药率分别为40%和70%左右,对氨苄西林的耐药率分别为15%和90%左右。对于肠球菌属细菌感染的治疗,主要依据青霉素(或氨苄西林)的敏感性,可预报其对氨苄西林、阿莫西林、氨苄西林-舒巴坦、阿莫西林-克拉维酸、哌拉西林、哌拉西林-他唑巴坦和亚胺培南敏感。粪肠球菌中氨苄西林药敏可预测亚胺培南的药敏结果。对产VRE患者,加做利奈唑胺、替加环素、氯霉素、红霉素、四环素和利福平药敏试验,根据结果进行治疗。
二、屎肠球菌 E. faecium
(一) 屎肠球菌形态与染色
革兰阳性球菌,菌体直径0.6~2.0μm,单个、成双或短链排列(图 6),菌血症或脓毒血症患者血培养标本涂片查见革兰阳性球菌(图 7)。

图 6 屎肠球菌纯培养的镜下形态(革兰染色)

图 7 屎肠球菌血培养标本的涂片(革兰染色)
(二) 屎肠球菌培养特性
在血琼脂平板上35℃培养18~24 h,形成灰白色、不透明、表面光滑、直径0.5~1 mm大小的圆形菌落(图 8)。
图 8屎肠球菌在血琼脂平板上的菌落特征(18~24h)
(三) 屎肠球菌生化反应
触酶试验阴性,在含6.5% NaCl的肉汤中生长,多数菌株PYR试验阳性,对杆菌肽耐药。主要生化反应见表 6。
(四) 屎肠球菌鉴别要点
- 本菌特征 革兰阳性球菌,触酶试验阴性,在6.5% NaCl中生长,胆汁七叶苷试验阳性,45℃中生长。
- 与粪肠球菌的鉴别 两者镜下形态相似(图12-7-9),鉴别见表12-7-7。
| 试验 | 结果 | 试验 | 结果 |
|---|---|---|---|
| 甘露醇 | +* | 色素 | — |
| 山梨糖 | — | 蔗糖 | +* |
| 精氨酸双水解酶 | + | 丙酮酸盐 | — |
| 阿拉伯糖 | + | MGP | — |
| 山梨醇 | V | 海藻糖 | + |
| 鼠李糖 | V | 木糖 | —* |
| 0.04%亚硝酸盐生长 | — | GAL | V |
注: +,90%或以上的菌株呈阳性; —,90%或以上的菌株呈阴性; V,反应不定。MGP,甲基-α-D-吡喃葡萄糖苷;GAL,2-硝基-b-d-吡喃半乳糖苷。*,偶见个例(<3%的菌株表现出非典型反应)

图 9屎肠球菌与粪肠球菌的镜下形态左图为屎肠球菌,右图为粪肠球菌
| 菌名 | 阿拉伯糖 | 山梨醇 | 0.04%亚硝酸盐生长 | 丙酮酸盐 |
|---|---|---|---|---|
| 屎肠球菌 | + | V | — | — |
| 粪肠球菌 | — | + | + | + |
注: +,90%或以上菌株呈阳性; —,90%或以上菌株呈阴性; V,可变(11%~89%菌株阳性)
(五) 屎肠球菌药敏试验的药物种类选择
屎肠球菌药敏试验的药物种类选择参见粪肠球菌章节
(六) 屎肠球菌结果解释与要点提示
屎肠球菌属肠球菌属.是人及动物肠道中正常菌群,对人体肠道菌群具有调控作用。
三、铅黄肠球菌 E. casseliflavus
(一) 铅黄肠球菌形态与染色
革兰阳性球菌,菌体直径为0.6~2.0μm,圆形或卵圆形,呈单个、成对或短链状排列,无荚膜,无芽胞(图 10)。
图 10 铅黄肠球菌纯培养的镜下形态(革兰染色)
(二) 铅黄肠球菌培养特性
在血琼脂平板上35℃培养18~24 h,形成黄色、湿润、凸起、α溶血的菌落(图 11)。
图 11铅黄肠球菌在血琼脂平板上的菌落特征(18~24h)
(三) 铅黄肠球菌生化反应
触酶试验阴性,分解甘露醇、阿拉伯糖、蔗糖,不分解山梨糖,精氨酸双水解酶、动力阳性,42℃生长,对万古霉素耐药。主要生化反应见表12-7-8。
(四) 铅黄肠球菌鉴别要点
- 本菌特征 革兰阳性球菌,触酶试验阴性,有黄色色素,分解蔗糖,动力阳性。
- 与鹑鸡肠球菌的鉴别 两者镜下形态相似(图 12),但铅黄肠球菌产色素,鹑鸡肠球菌则不产色素(图 13)。其他鉴别的关键性试验见表 9。<
| 试验 < | 结果 < | 试验 < | 结果 |
|---|---|---|---|
| 甘露醇 | + | 色素 | +* |
| 山梨糖 | — | 蔗糖 | + |
| 精氨酸双水解酶 | +* | 丙酮酸盐 | V |
| 阿拉伯糖 | + | MGP | + |
| 山梨醇 | V | 海藻糖 | + |
| 鼠李糖 | + | 木糖 | + |
| 0.04%亚硝酸盐生长 | —* | GAL | + |
注: +,90%或以上的菌株呈阳性; —,90%或以上的菌株呈阴性; V,可变(11%~89%的菌株阳性);MGP,甲基-α-D-吡喃葡萄糖苷;GAL,2-硝基-b-d-吡喃半乳糖苷。*,偶见个例(<3%的菌株表现出非典型反应)

图 12 铅黄肠球菌与鹑鸡肠球菌的镜下形态左图为铅黄肠球菌:右图为鹑鸡肠球菌
图 13 铅黄肠球菌与鹑鸡肠球菌在血琼脂平板上的菌落特征左图为铅黄肠球菌:右图为鹑鸡肠球菌<
| 菌名 < | 山梨醇 < | 黄色素 < | α溶血 < | 丙三醇 |
|---|---|---|---|---|
| 铅黄肠球菌 | V | + | + | V |
| 鹑鸡肠球菌 | — | — | — | — |
注: +,90%以上菌株阳性; —,90%以上菌株阴性; V,11%~89%菌株阳性
3. 与其他产黄色色素的肠球菌鉴别
见表 10。<
| 菌名 < | 甘露醇 < | 山梨糖 < | 精氨酸双水解酶 < | 阿拉伯糖 < | 山梨醇 < | 动力 < | 色素 < | 丙酮酸盐 < | 木糖 |
|---|---|---|---|---|---|---|---|---|---|
| 蒙特勒球菌 | + | — | + | + | V | — | + | V | + |
| 铅黄肠球菌 | + | — | + | + | V | + | + | V | + |
| 浅黄肠球菌 | + | + | — | — | + | — | + | + | — |
| 亮黄肠球菌 | + | + | — | + | + | — | + | + | — |
| 硫黄肠球菌 | — | — | — | — | — | — | + | V | — |
注: +,90%以上菌株阳性; —,90%以上菌株阴性; V,11%~89%菌株阳性
(五) 铅黄肠球菌药敏试验的药物种类选择
铅黄肠球菌药敏试验的药物种类选择参见鹑鸡肠球菌章节。该菌对万古霉素天然耐药。
(六) 铅黄肠球菌结果解释与要点提示
铅黄肠球菌为人和动物胃肠道的正常菌群之一,可引起抵抗力低下宿主的多种机会感染。临床上不仅可引起尿路感染、皮肤软组织感染,还可引起危及生命的腹腔感染、脓毒症、心内膜炎和脑膜炎等。
四、鹑鸡肠球菌 E. gallinarum
(一) 鹑鸡肠球菌形态与染色
革兰阳性球菌,圆形或卵圆形,呈单个、成双或短链状排列,无荚膜,无芽胞(图 14)。
图 14 鹑鸡肠球菌纯培养的镜下形态(革兰染色)
(二) 鹑鸡肠球菌培养特性
在血琼脂平板上35℃培养18~24 h,形成灰白色、湿润、凸起的菌落(图12-7-15)。
图 15 鹑鸡肠球菌在血琼脂平板上的菌落特征(18~24h)
(三) 鹑鸡肠球菌生化反应
触酶试验阴性,主要生化反应见表 11。<
| 试验 < | 结果 < | 试验 < | 结果 |
|---|---|---|---|
| 甘露醇 | + | 色素 | — |
| 山梨糖 | — | 蔗糖 | + |
| 精氨酸双水解酶 | +* | 丙酮酸盐 | V |
| 阿拉伯糖 | + | MGP | + |
| 山梨醇 | — | 海藻糖 | + |
| 鼠李糖 | + | 木糖 | + |
| 0.04%亚硝酸盐生长 | — | GAL | + |
注: +,90%或以上菌株呈阳性; —,90%或以上菌株呈阴性; V,可变(11%~89%菌株阳性)。MGP,甲基-α-D-吡喃葡萄糖苷;GAL,2-硝基-b-d-吡喃半乳糖苷。*,偶见个例(<3%的菌株表现出非典型反应)
(四) 鹑鸡肠球菌鉴别要点
- 本菌特征 革兰阳性球菌,触酶试验阴性,分解蔗糖、甘露醇,动力阳性。
- 鉴别诊断 与屎肠球菌、铅黄肠球菌、粪肠球菌的鉴别见表12-7-12。<
| 菌名 < | 阿拉伯糖 < | 山梨醇 < | 棉子糖 < | 动力 < | 色素 < | 丙酮酸盐 < | MGP < | 木糖 |
|---|---|---|---|---|---|---|---|---|
| 屎肠球菌 | + | V | V | — | — | — | — | —* |
| 铅黄肠球菌 | + | V | + | +* | +* | V | + | + |
| 粪肠球菌 | — | + | — | — | — | + | — | —* |
| 鹑鸡肠球菌 | + | — | + | +* | — | V | + | + |
注: +,90%以上菌株阳性; —,90%以上菌株阴性; V,11%~89%菌株阳性。MGP,甲基-α-D-吡喃葡萄糖苷。*,偶见个例(<3%的菌株表现出非典型反应)
(五) 鹑鸡肠球菌药敏试验的药物种类选择
鹑鸡肠球菌药敏试验的药物种类选择见表 13。<
| < | 抗菌药物名称 |
|---|---|
| 必选 | 青霉素、氨苄西林 |
| 可选 | 达托霉素、利奈唑胺、特地唑胺 |
| 天然耐药 | 头孢菌素类*、氨基糖苷类*、克林霉素*、奎奴普丁-达福普汀、甲氧苄啶、复方磺胺甲噁唑*、夫西地酸、氨曲南、多黏菌素B/黏菌素、萘啶酸、万古霉素 |
备注: *对于肠球菌属,头孢菌素类、氨基糖苷类抗菌药物(除高水平耐药筛查)、克林霉素和复方磺胺甲噁唑体外试验可表现出活性,但临床无效,所以不应报告敏感。建议泌尿系感染报告的药物: 四环素、环丙沙星、诺氟沙星、左氧氟沙星、呋喃妥因
(六) 鹑鸡肠球菌结果解释与要点提示
鹑鸡肠球菌是人和禽兽类肠道中的正常菌群,临床标本中很少分离到,人类血液或骨髓中更为少见。其在机体免疫力低下时可入侵血液引发脓毒症,国内报道甚少。
参考文献
周庭银, 章强强 主编. 临床微生物学诊断与图解(第4版)[M]. 上海: 上海科学技术出版社, 2019.
相关产品
HZB220603:粪肠球菌 | Enterococcus faecalis (119-10)
HZB356260:屎肠球菌ATCC 51559 | Enterococcus faecium (MMC4)
HZB361407:铅黄肠球菌ATCC 700327 | Enterococcus casseliflavus (9199)
敬请关注灰藻生物,共筑健康未来!
— 武汉市灰藻生物科技有限公司团队敬上
灰藻生物:我们期待着与客户共同成长,共创生命科学的美好未来!
更新日期:2026-1-9
编制人:木木
审稿人:小藻